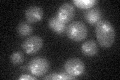
YDR227W
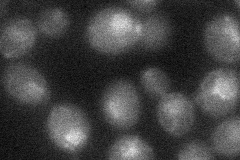
YDR227W
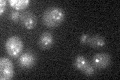
YDR227W

View description
Silent information regulator that, together with SIR2 and SIR3, is involved in assembly of silent chromatin domains at telomeres and the silent mating-type loci; potentially phosphorylated by Cdc28p; some alleles of SIR4 prolong lifespan
Localization:
Intensity:
Fold change:
Significance:
-
C’ GFP library in SD
nuclear periphery20.63 -
N' NOP1pr-GFP in SD

punctate,nucleus49.5599 -
N' TEF2pr-mCherry in SD

nucleus16.8144 -
N' NATIVEpr-GFP in SD

punctate,nuclear periphery32.0982 -
N' TEF2pr-VC and Cyto-VN in SD
nucleus27.2266 -
C’ GFP library in SD+DTT

nuclear periphery19.270.93No -
C’ GFP library in SD+H2O2

nuclear periphery25.161.21No -
C’ GFP library in Starvation Media
nuclear periphery19.270.93No -
C’ GFP library on the background of Pup2-DaMP

nuclear periphery -
C’ GFP library on the background of CCT mutant

nuclear periphery21.98951.06559No
